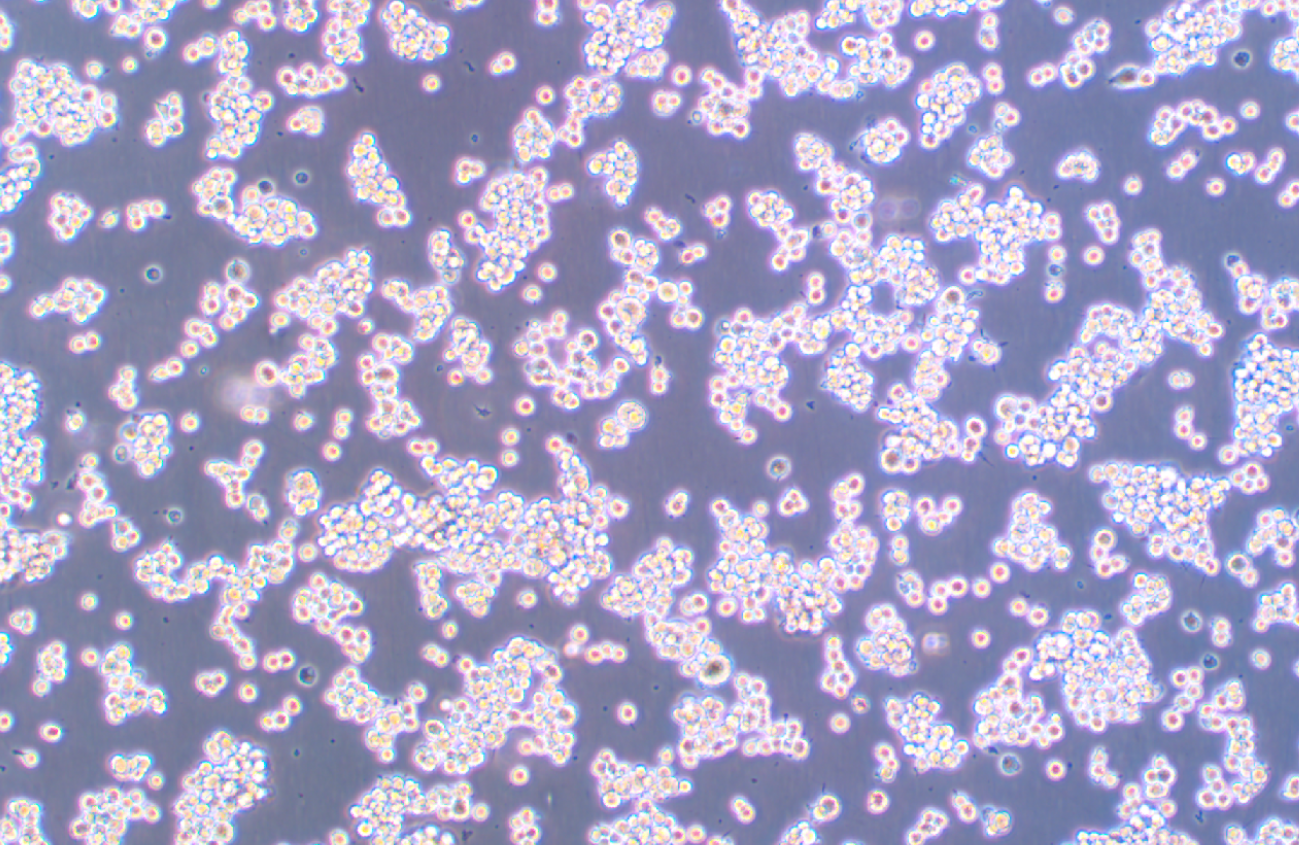
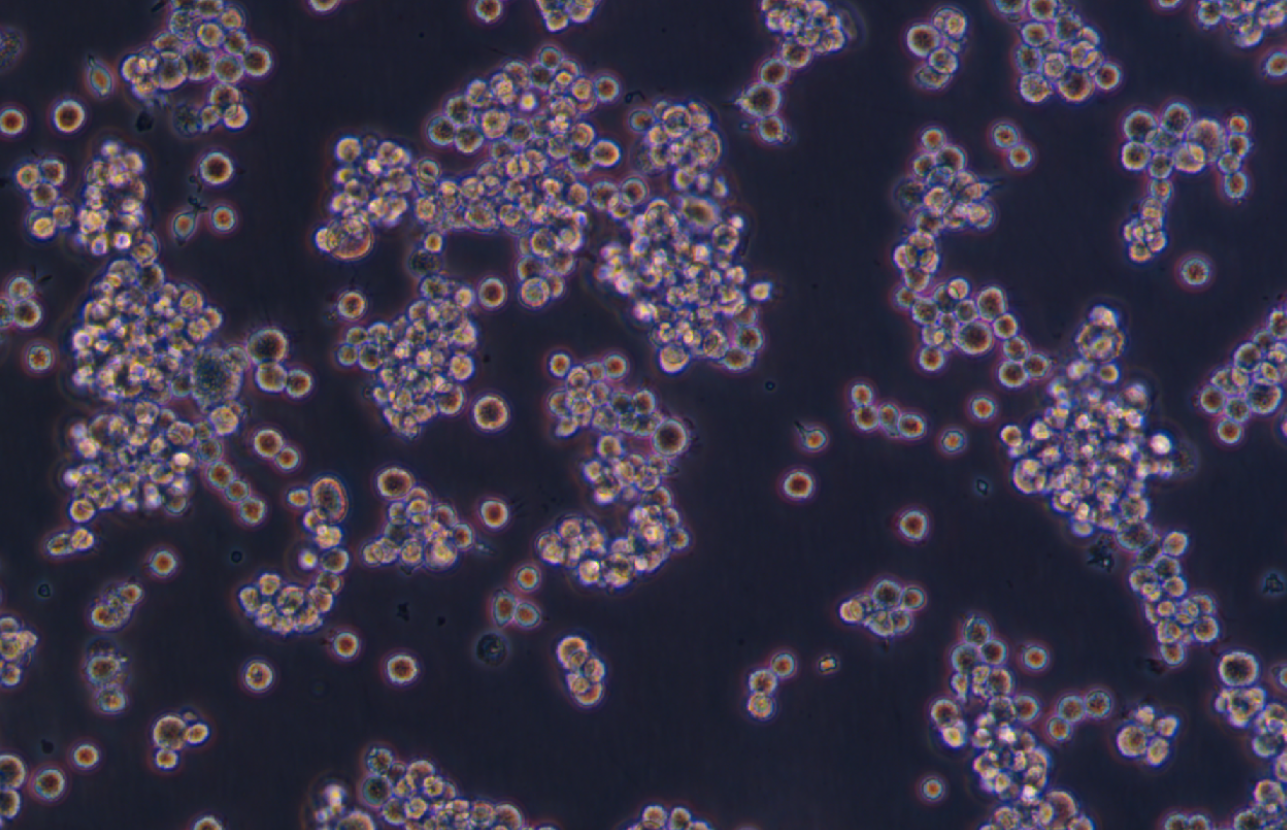

|
種屬 |
大鼠 |
|
別稱 |
NR-8383; NR 8383; NR8383.1; AgC11x3A; Normal Rat, August 3, 1983 |
|
組織來源 |
肺;肺泡 |
|
疾病 |
自發永生細胞系 |
|
傳代比例/細胞消化 |
1:2傳代,懸浮部分離心收集(1000RPM,5分鐘) ,貼壁部分消化1-2分鐘 |
|
完全培養基配置 |
Ham's F-12K培養基; 20%胎牛血清;1%雙抗 |
|
簡介 |
NR8383細胞來源于肺灌洗時的正常大鼠肺泡巨噬細胞 ,NR8383細胞在Gerbil肺細胞連續培養液存在下培養了8-9個 月。隨后 ,NR8383細胞不再需要外源生長因子。通過有限稀釋法 ,從單個細胞克隆并亞克隆NR8383細胞 ,并3次用 軟瓊脂亞克隆。 NR8383細胞表現出巨噬細胞的特性:吞噬酵母多糖和銅綠、非特異性脂酶活性、 Fc受體、氧化降解;分泌IL-1、TNF-β和IL-6 ,可重復地響應外源生長因子。NR8383細胞響應博萊霉素 ,分泌TNF-β前體。 NR8383細胞在博萊霉素刺激下 ,TNF-β mRNA表達也上升。NR8383細胞對內毒素敏感 ,1-10ng/ml的LPS水平抑 制增生達50%。即使達到0.001mg/ml的水平 ,LPS抑制還是無毒且在后續過程中可逆的。 NR8383細胞提供了高響 應的肺泡巨噬細胞的均一來源 ,可以用于體外研究巨響細胞相關活性 |
|
形態 |
巨噬細胞樣 |
|
生長特征 |
貼壁 ,懸浮混合生長 |
|
倍增時間 |
每周 2 至 3 次 |
|
培養條件 |
氣相:空氣 ,95%;二氧化碳 ,5%。 溫度:37攝氏度 ,培養箱濕度為70%-80%。 |
|
凍存條件 |
凍存液:90%FBS ,DMSO 10%, 或使用非程序凍存液:官網貨號JY-H040 |
|
保藏機構 |
ATCC; CRL-2192 |
|
備注 |
該細胞為半懸浮和半貼壁細胞 ,懸浮細胞離心收集 ,貼壁細胞消化處理 |
|
產品使用 |
僅限于科學研究 ,不可作為動物或人類疾病的治療產品使用。 |